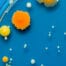
Proba, celule, stem, contaminata,

Utilizăm tehnologii precum modulele cookie pentru a stoca și/sau a accesa informațiile despre dispozitiv. Facem acest lucru pentru a îmbunătăți experiența de navigare și pentru a afișa reclame (ne)personalizate. Consimțământul pentru aceste tehnologii ne va permite să procesăm date precum comportamentul de navigare sau ID-uri unice pe acest site. Neacordarea sau retragerea consimțământului, poate afecta în mod negativ anumite caracteristici și funcții.
Stocarea tehnică sau accesul este strict necesar în scopul legitim de a permite utilizarea unui serviciu specific solicitat în mod explicit de către abonat sau utilizator sau în unicul scop de a realiza transmiterea unei comunicări prin intermediul unei rețele de comunicații electronice.
The technical storage or access is necessary for the legitimate purpose of storing preferences that are not requested by the subscriber or user.
The technical storage or access that is used exclusively for statistical purposes.
Stocarea sau accesul tehnic care este utilizat exclusiv în scopuri statistice anonime. În lipsa unei citații, a unei conformări voluntare din partea furnizorului dvs. de servicii de internet sau a unor înregistrări suplimentare de la o terță parte, informațiile stocate sau recuperate numai în acest scop nu pot fi utilizate, de obicei, pentru a vă identifica.
Stocarea sau accesul tehnic este necesar pentru a crea profiluri de utilizator pentru a trimite publicitate sau pentru a urmări utilizatorul pe un site web sau pe mai multe site-uri web în scopuri similare de marketing.

No Comment